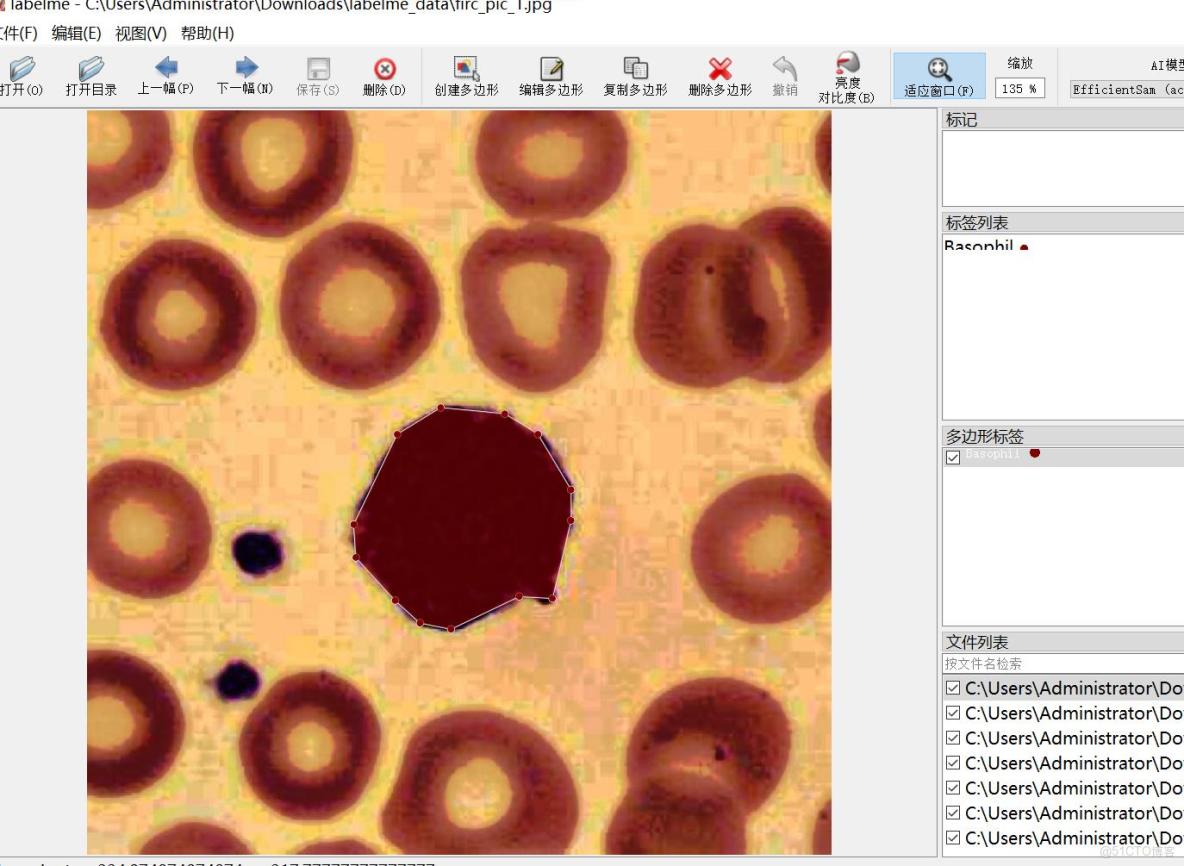
癌症檢測血細胞識別分割數據集labelme格式4918張5類別_json數據_05

數據集格式:labelme格式(不包含mask文件,僅僅包含jpg圖片和對應的json文件)
圖片數量(jpg文件個數):4918
標註數量(json文件個數):4918
標註類別數:5
標註類別名稱:["Basophil","Erythroblast","Monocyte","Myeloblast","Seg_Neutrophil"]=>["嗜鹼性粒細胞","幼紅細胞","單核細胞","原粒細胞","分葉核中性粒細胞"]
每個類別標註的框數:
Basophil count = 977
Erythroblast count = 1108
Monocyte count = 973
Myeloblast count = 980
Seg_Neutrophil count = 982
總框數:5020
使用標註工具:labelme=5.5.0
所在倉庫:firc-dataset
圖片分辨率:640x640
標註規則:對類別進行畫多邊形框polygon
重要説明:可以將數據集用labelme打開編輯,json數據集需自己轉成mask或者yolo格式或者coco格式作語義分割或者實例分割
特別聲明:本數據集不對訓練的模型或者權重文件精度作任何保證
圖片預覽:
標註例子:
原圖:
標註繪製結果:
labelme編輯圖實例:
labelme格式實例:
{
"version": "5.5.0",
"flags": {},
"shapes": [
{
"label": "Myeloblast",
"points": [
[
133.106,
268.218
],
[
126.562,
288.63
],
[
128.674,
303.843
],
[
134.4,
337.6
],
[
163.126,
405.256
],
[
190.838,
435.298
],
[
227.403,
453.398
],
[
242.798,
453.398
],
[
272.819,
464.184
],
[
290.91,
465.723
],
[
317.853,
466.494
],
[
355.957,
454.555
],
[
379.434,
439.918
],
[
389.826,
441.459
],
[
401.758,
437.608
],
[
409.84,
422.973
],
[
403.298,
402.944
],
[
404.8,
372.8
],
[
414.4,
337.6
],
[
411.2,
321.6
],
[
408.301,
305.886
],
[
404.067,
295.102
],
[
397.139,
283.163
],
[
388.286,
277.075
],
[
384.053,
267.061
],
[
389.056,
256.662
],
[
387.517,
249.73
],
[
376,
249.6
],
[
355.957,
221.998
],
[
338.251,
198.12
],
[
300.91,
183.101
],
[
272.045,
181.944
],
[
246.642,
184.254
],
[
221.048,
191.187
],
[
182.942,
211.6
],
[
148.885,
248.189
],
[
133.106,
268.218
]
],
"group_id": null,
"shape_type": "polygon",
"flags": {}
}
],
"imagePath": "firc_pic_3882.jpg",
"imageData": null,
"imageHeight": 640,
"imageWidth": 640
}